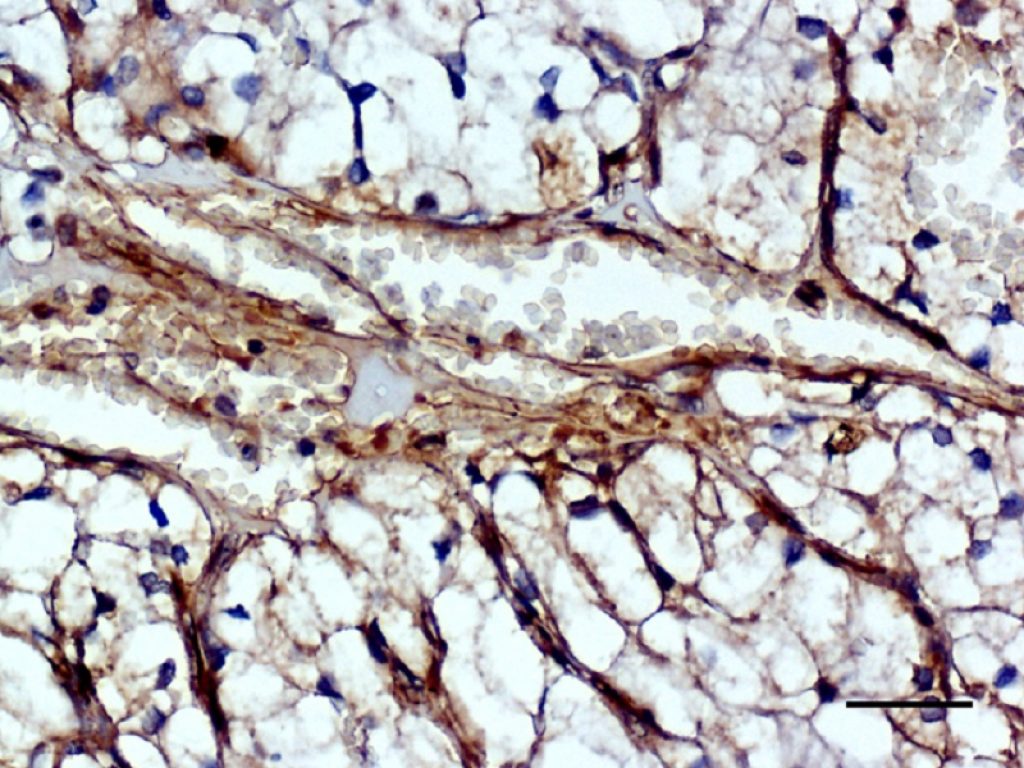
Tumori solidi: l’inattivazione della proteina MICAL2 “disabilita” la risposta delle cellule verso un attore della loro crescita e impedisce la formazione di nuovi vasi sanguigni per “nutrirli”

Tumori solidi: l’inattivazione della proteina MICAL2 “disabilita” la risposta delle cellule verso un attore della loro crescita e impedisce la formazione di nuovi vasi sanguigni per “nutrirli”
Ricercatori del Laboratorio di Scienze Mediche dell’Istituto di Scienze della Vita della Scuola Superiore Sant’Anna di Pisa, guidati dalla biologa molecolare Debora Angeloni, hanno scoperto un nuovo tassello utile a comprendere lo sviluppo dei tumori solidi, la parte maggiore di quelli che colpiscono gli esseri umani. Si tratta dei risultati di una ricerca di base che aggiungono un nuovo elemento alla possibilità di aggredire il tumore. Ovviamente soltanto ulteriori e più approfonditi studi potranno verificare la possibilità di arrivare ad applicazioni terapeutiche. Lo studio che ha portato a questa scoperta, validata senza condurre test su animali, è stato pubblicato sulla rivista internazionale “Biochimica et Biophysica Acta – Molecular Basis of Disease”.
Colpendo una proteina, peraltro già nota ai ricercatori italiani e detta MICAL2, è possibile “disabilitare” la risposta delle cellule verso un attore di crescita tumorale che si chiama VEGF (fattore di crescita dell’endotelio vascolare) e che rappresenta il principale bersaglio delle attuali terapie anti-angiogeniche, ovvero anti tumorali. Infatti, le cellule tumorali sono particolarmente resistenti e versatili: la capacità di indurre neo-angiogenesi, cioè la formazione di nuovi vasi sanguigni verso il tumore, è un “assodato segno distintivo” – così lo definiscono i ricercatori – delle cellule tumorali.
Anche se la dimostrazione per adesso è limitata all’ambito sperimentale, l’inattivazione della proteina MICAL2 nelle cellule endoteliali (quel tipo di cellule che tappezza dall’interno i vasi sanguigni) ottiene di ridurre vitalità e prestazioni funzionali delle stesse, bloccando in prospettiva la capacità di formazione di nuovi vasi sanguigni associati al tumore (il processo cosiddetto di neo-angiogenesi), e dunque, lo sviluppo del tumore solido.
“Da molti anni – commenta Debora Angeloni – la ricerca mira a coniugare alle terapie antitumorali, farmaci ad azione anti-angiogenica. I farmaci attuali però continuano a presentare effetti collaterali, efficacia temporanea e problemi di resistenza primaria. Occorre pertanto identificare nuovi bersagli terapeutici, cioè nuovi componenti presenti in modo anomalo nella cellula malata rispetto a quella normale, la cui inattivazione permetta di recuperare la normalità. I MICAL sono una famiglia unica di proteine che hanno la capacità di modificare una componente importante del citoscheletro, cioè di quella sorta di impalcatura della cellula che le permette di interagire con le cellule circostanti, di aderire ad una superficie e di muoversi, e rappresentano candidati promettenti per questo ruolo di nuovo bersaglio”.
Questa scoperta è stata sostenuta grazie anche alle donazioni liberali di numerosi cittadini e di associazioni come il Lions Club International, Distretto 108LA, Toscana. “A tutti loro – conclude Debora Angeloni – va il nostro ringraziamento per il generoso sostegno e la garanzia del nostro massimo impegno nel portare avanti queste ricerche”.